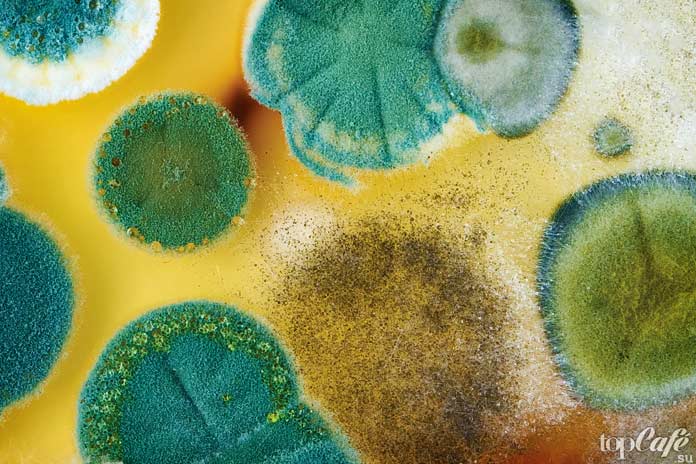
Плесень
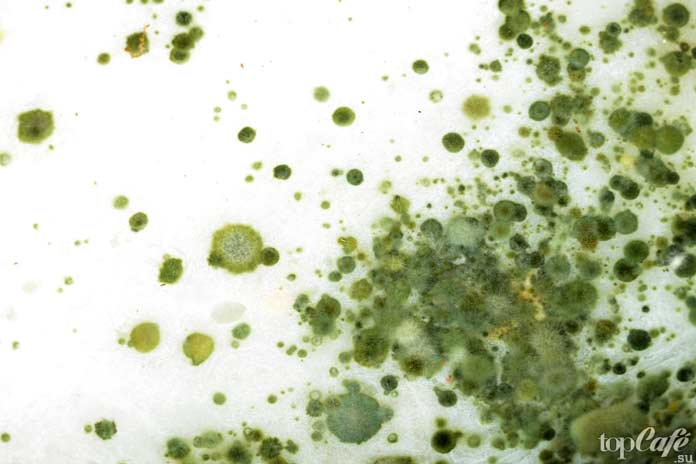
Плесень

Альбинизм довольно распространённое явление в живой природе. У животных это вызвано отсутствием пигмента меланина, а у растений — хлорофилла. Встречаются и люди альбиносы с полностью белой кожей, волосами и красной радужной оболочкой глаз. Проведём небольшое исследование, и узнаем, кто такие альбиносы.
Немного истории

Название природной аномалии происходит от латинского слова albus, что в переводе на другие языки означает «белый». Первые описания альбинизма у людей и животных встречаются ещё в медицинских трактатах Древней Греции и Рима.
В Средневековье такие люди преследовались, так как считались сторонниками тёмных сил. Казалось бы, парадокс. Белые люди и поборники тёмных сил. Но дело в том, что страдающие альбинизмом люди сложно переносят дневной свет, что и становилось причинами обвинения в колдовстве.
Причины возникновения

Сначала выясним причины проявления такого природного феномена. Причиной становится отсутствие в организме фермента тирозиназа, который активно участвует в синтезе меланина.
Это с точки зрения анатомии, а вот в медицине выделяют наследственность и осложнения после перенесённых опасных заболеваний. Ген альбинизма передаётся по наследству. Медики выделяют 10 групп людей, у которых проявляется данная природная аномалия.
Самыми распространёнными являются первые две. Первая, это когда у человека полностью белые кода и волосы. Обычно, такие люди страдают плохим зрением. И вторая группа, это люди с желтоватым или розовым цветом кожи, которая с возрастом светлеет практически до белого.
Виды альбинизма различны, но это не болезнь.
Статистика

Наука практически установила, почему рождаются люди альбиносы, а вот, что нам говорит статистика.
Среди европейских народов 1 альбинос приходится на 20 тысяч жителей Европы. Интересно, что лидеры по этому показателю африканцы. А всего на планете 1% таких необычных людей от всей численности населения Земли.
У большинства людей в организме есть ген альбинизма, но он не активен. С такой скрытой аномалией, как заявляют учёные, живёт каждый 70-й человек планеты.
Семейные кланы

Таких необычных людей ещё называют «Дети Луны». Они всегда привлекали внимание, а в прошлом, да и в настоящем их используют в цирковых и эстрадных представлениях.
Причиной распространения альбинизма в небольших этнических группах обусловлен частыми родственными браками. Всего на земле около 700 таких родословных семей. Так, у коренных жителей Панамы индейцев племени куна каждый 150 ребёнок рождается альбиносом. Есть такой регион «белых людей» и в Северной Ирландии.
Читайте также: Красивые и знаменитые чернокожие актрисы.
Мифы и легенды

Альбиносам действительно вреден солнечный свет, так у них ослабленный иммунитет и прямые солнечные лучи могут вызвать рак кожи. Для жителя средневековой Европы это выглядело странно, что люди стараются держаться в тени.
Считалось, что их красноватые глаза светятся в темноте. Из-за этого их часто сравнивали с вампирами. В Европе рождались невероятные мифы и легенды о людях-альбиносах. Отношения менялись от преследований до слепого поклонения людям с необычной и таинственной внешностью.
Люди альбиносы

Многие настороженно, и даже с опаской относятся к таким людям. Есть в них что-то таинственное и загадочное. Таким людям нелегко адаптироваться в мире, ведь всё странное вызывает у обычных людей страх. Но вопреки стереотипам многие «белые вороны» добились успеха, став знаменитыми моделями.
1. Джуэлл Джеффри / Jewell Jeffrey

Модель-альбинос, который штурмует мир моды. Кроме того, Джуэлл известный ди-джей по прозвищу Fashion killer. На его аккаунты в социальных сетях подписаны десятки тысяч поклонников.
2. Тандо Хопа / Thando Hopa

Знаменитая фотомодель из Южной Африки. Её фотографии украшают обложки ведущих глянцевых журналов, а также она официальное лицо косметического бренда «Vichy». Женщина стала своеобразным символом преодоления негативного отношения к альбинизму.
3. Настя Жидкова / Nastya Zhidkova

Российская Белоснежка родилась в Москве, и окончила юридический факультет Московского университета. Нестандартная внешность привела Настю в мир моды. Её фотосессии часто появляются на страницах журналов, а лучшие Дома моды приглашают её на свои показы одежды.
4. Конни Чиу

Китаянка первая из необычных белых людей протоптала дорожку в модельный бизнес. Она первая в мире девушка-альбинос, которую пригласили в рекламные фотосессии и на подиум. А начиналось всё с того, что сестра привела Конни на одно из телевизионных шоу.
5. Албино Рефилве Модиселл

Уроженка ЮАР с идеально белой кожей, глазами цвета льда использует любую возможность, чтобы стать самой известной моделью. Девушка, которая по собственному выражению «живёт в коже белого человека, уже стала новым лицом мировой индустрии моды.
6. Амаль Софи

Парень с белоснежной кожей и белыми волосами только начинает свой путь в модельном бизнесе, но уже покорил целую армию поклонников своей необычной внешностью. У него есть собственные страницы в социальных сетях, а в интернете его фотографии собирают десятки тысяч лайков.
7. Стивен Томпсон

Стивен родился в ЮАР, а вот успеха добился в Нью-Йорке, став ведущей моделью агентства «Major Model Management». Не путать с известным бойцом смешанных единоборств, который является полным тёзкой модели с необычной внешностью.
8. Алёна Субботина

Красавица Алёна родилась в Казахстане, а вот успешную карьеру модели делает в странах Европы и США. В 2013 году необычную девушку пригласили на показ модного итальянского бренда «Brunello Cucinelli», сделав модель-альбиноса официальным лицом фирмы.
9. Сэр Майор / Sir Major

Модель с необычной внешностью из Африки взял себе довольно звучный и известный в истории творческий псевдоним. Среди других подобных моделей Майора выделяет пронзительный, и, можно сказать, жёсткий взгляд. Ведь у него, несвойственные для такого типа людей карие глаза.
10. Дессислава / Dessyslava

Модель из Болгарии выглядит как очаровательная мечтательница. Её имя означает, что девушка независима, любит путешествовать. А ещё, обладая аналитическим складом ума, найдёт выход из любой сложной ситуации. А по внешности и не скажешь.
11. Диандра Форрест / Diandra Forrest

Афроамериканская модель родилась в Нью-Йорке. У неё светлая кожа с невероятно большие зелёные глаза и выразительный аристократичный лоб. Принимает участие в показах одежды, рекламных фотосессиях и снимается в клипах известных поп-музыкантов.
12. Шон Росс / Shaun Ross

Профессиональная модель кроме выступлений на подиуме, активно реализовывает себя на театральной сцене и в танце. Шон уже попробовал свои силы в большом кино, сыграв ряд ролей второго плана.
13. Тихиро / Tihiro

Есть свои популярные модели с необычной внешностью и в Азии. Азиаты с белой кожей довольно частое явление. Так, очаровательная модель из Японии Тихиро покорила мир своей неповторимостью и загадочным восточным образом.
Читайте также: Самые красивые японки в мире.
Альбиносы в обычной жизни

Возможно, встретить альбиноса это к счастью. Ведь это светлые, и на вид совершенно безобидные люди. Пройдёмся по улицам городов мира, чтобы представить фотографии красивых людей.
Читайте также: ТОП-10 трагических фактов про людей-альбиносов в Африке.
Дети альбиносы
Представим ещё фото милых деток, которые похожи на ангелочков. Такие дети рождаются в разных этнических группах, но учёные отмечают, что больше всего таких людей в Мексике, африканских странах и Сицилии, Ирландии.
1. Девочка из Якутии

2. Снежная красавица из Соединённых Штатов

3. Ещё одна белоснежная девочка с голубыми глазами по имени Луиза, живущая в США

4. Белокурый мальчик с белыми кудрявыми волосами и огромными голубыми глазами-озерами

Преследование

Необычная внешность таких людей часто вызывает насмешки, а порой и крайне негативное отношение. Всё это испытывают на себе африканские альбиносы. Родиться белым в этой части планеты, это значит подвергнуть себя смертельной опасности.
В истории зафиксировано множество случаев, когда из-за необычного цвета кожи, волос и красных глаз людей в Африке убивали. Охота на таких людей и убийство альбиносов частое явление в Танзании. Самое страшное, что это явление начинает распространяться и в других регионах планеты.
Интересные факты про альбиносов
Представив основные данные об альбинизме, закончим наш рассказ интересными фактами о самой аномалии и о людях с такой запоминающейся внешностью.
Здоровье

Это миф, что альбиносы долго не живут. Отсутствие меланина не сказывается на продолжительности жизни и физическом росте. Не влияет это и на интеллектуальном развитии человека.
Но у них наблюдается слабое зрение, плохая свёртываемость крови, повышенная вероятность получить рак кожи. Встречается среди альбиносов синдром Германского-Пудлака. Он приводит к частым кровотечениям и болезням лёгких.
Читайте также: ТОП-10 советов о том, как ухаживать за кожей зимой.
Лекарство

Альбинизм наследственное заболевание. Но вот пока, медики не нашли лекарственного препарата от альбинизма.
Можно операционным путём снизить влияние гена, но такие операции запрещены на людях. Гены тесно взаимосвязаны, и воздействие на один из них, может нарушить стройную систему.
Общественные организации

В мире существуют различные объединения. Есть, оказывается, и «Союз бесцветных», в который объединены альбиносы.
В Малави активисты добились регистрации на государственном уровне организации «Albino Association of Malawi». Сфера деятельности — это поддержка людей с необычной внешностью.
Многие такие организации в Африке создают сеть клиник и консультативные пункты для родителей, у которых воспитываются дети-альбиносы.
Цвет глаз

В обществе достаточно сильно распространён стереотип, что у альбиносов только красные или розовые глаза. На самом деле, цвет глаз у них может быть различным, от светло-серого до ярко-синего.
На самом деле, у многих глаза прозрачные, а красноватость придаёт отражение от задней стенки глазного яблока. Своеобразный естественный эффект «красных глаз» на фото.
Читайте также: Люди с самыми красивыми глазами в мире.
Синтез витамина

Люди-альбиносы синтезируют Витамин D в пять раз быстрее, чем темнокожие. Прозрачность кожи способствует проникновению ультрафиолета. Это условие и приводит к образованию витамина данной группы.
Витилиго

Есть особая форма, когда лишь отдельные участки кожи теряют пигментацию. Медики именуют это генетическое заболевание витилиго, а среди известных людей страдающих такой формой был Майкл Джексон. Такой необычный «недостаток» канадская модель Винни Харлоу сделала своей изюминкой.
Читайте также: Полезные советы дерматологов для здоровья и красоты кожи.
Заключение

В завершение topcafe.su отмечает, что цвет кожи, этническая принадлежность и индивидуальные особенности организма не должны становиться поводом для дискриминации. В истории человечества есть трагические страницы, когда деление по расовому признаку, признание исключительности одной из наций приводили к трагическим событиям, и стали причиной жестокого преследования, а порой и полного истребления целых народов.
И ещё несколько фотографий людей альбиносов:



На этом всё! Спасибо за внимание.
]]>






 Среди змей альбинизм довольно редкое явление. Отсутствие меланина никак не влияет на их образ жизни и поведение. Это необычное зрелище, но таким белым змеям сложнее спрятаться среди камней или песков пустыни.
Среди змей альбинизм довольно редкое явление. Отсутствие меланина никак не влияет на их образ жизни и поведение. Это необычное зрелище, но таким белым змеям сложнее спрятаться среди камней или песков пустыни.















































































































































































































































































































































































































































































 Довольно высокий уровень интеллекта по собачьим меркам — несмотря на миниатюрные размеры головки, у этих собак довольно высокий уровень интеллекта. Они демонстрируют внимательность, любознательность, быстро и легко поддаются дрессировке, при правильном воспитании демонстрируют отличные манеры.
Довольно высокий уровень интеллекта по собачьим меркам — несмотря на миниатюрные размеры головки, у этих собак довольно высокий уровень интеллекта. Они демонстрируют внимательность, любознательность, быстро и легко поддаются дрессировке, при правильном воспитании демонстрируют отличные манеры. Упрямство и настойчивость — понимать, что хочет йорк, всегда легко, так как он демонстрирует по отношению к своим целям повышенный интерес и весьма настойчив, когда заходит разговор об их достижении. Так что, если ваш йорк решил поиграть, он обязательно склонит к игре и вас. Вы и сами не заметите, как начнёте ему бросать мячик, который он будет вам приносить.
Упрямство и настойчивость — понимать, что хочет йорк, всегда легко, так как он демонстрирует по отношению к своим целям повышенный интерес и весьма настойчив, когда заходит разговор об их достижении. Так что, если ваш йорк решил поиграть, он обязательно склонит к игре и вас. Вы и сами не заметите, как начнёте ему бросать мячик, который он будет вам приносить. Независимость — довольно часто многие владельцы йоркширских терьеров сталкиваются со сложностями в процессе дрессировки и воспитания своих собак. Они демонстрируют свою независимость и отказываются выполнять команды. Как же так, ведь выше мы вспоминали об их послушании? Зоопсихологи говорят о том, что очень важно наладить контакт с животным и заслужить его уважение. Если вы добьётесь этого, йорк будет слушать вас беспрекословно, быстро выполнять все ваши команды.
Независимость — довольно часто многие владельцы йоркширских терьеров сталкиваются со сложностями в процессе дрессировки и воспитания своих собак. Они демонстрируют свою независимость и отказываются выполнять команды. Как же так, ведь выше мы вспоминали об их послушании? Зоопсихологи говорят о том, что очень важно наладить контакт с животным и заслужить его уважение. Если вы добьётесь этого, йорк будет слушать вас беспрекословно, быстро выполнять все ваши команды.